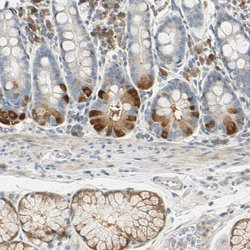

Promotional price valid on web orders only. Your contract pricing may differ. Interested in signing up for a dedicated account number?
Learn More
Learn More
Invitrogen™ WIPI1 Polyclonal Antibody


Rabbit Polyclonal Antibody
Supplier: Invitrogen™ PA552443
Description
Immunogen sequence: HQDRAFATAR LNFSGQRNIC TLSTIQKLPR LLVASSSGHL YMYNLDPQDG GECVLIKTHS LLGSGTTEEN KENDLRPSLP QSYAATVARP SASSASTVPG YSEDGGALRG EVIPEHEFAT GPVCLDDENE FPPIILCRG Highest antigen sequence identity to the following orthologs: Mouse - 94%, Rat - 94%.
WIPI1 (WD repeat domain, phosphoinositide interacting-1), also known as WIPI1, ATG18 or WIPI49, is thought to play a role in autophagy and may regulate protein trafficking in certain recycling pathways. It contains three WD repeats and has a 7-bladed propeller structure with a conserved motif that facilitates its interaction with other proteins. WIPI1 localizes to cytoplasmic vesicles, endosomes, clathrin-coated vesicles and the trans-Golgi network. It is ubiquitously expressed with highest expression in heart, testis, placenta, pancreas and skeletal muscle. WIPI1 is upregulated in a variety of tumors, suggesting a role in carcinogenesis.
Specifications
| WIPI1 | |
| Polyclonal | |
| Unconjugated | |
| WIPI1 | |
| 4930533H01Rik; ATG18; Atg18 protein homolog; ATG18A; AW411817; D11Ertd498e; RGD1307754; WD repeat domain phosphoinositide-interacting protein 1; WD repeat domain, phosphoinositide interacting 1; WD40 repeat protein interacting with phosphoinositides of 49 kDa; WD40 repeat protein Interacting with phosphoInositides of 49kDa; WIPI 49 kDa; Wipi1; WIPI-1; WIPI-1 alpha; WIPI49 | |
| Rabbit | |
| Antigen Affinity Chromatography | |
| RUO | |
| 303630, 52639, 55062 | |
| Store at 4°C short term. For long term storage, store at -20°C, avoiding freeze/thaw cycles. | |
| Liquid |
| Immunohistochemistry (Paraffin), Western Blot | |
| 0.1 mg/mL | |
| PBS with 40% glycerol and 0.02% sodium azide; pH 7.2 | |
| Q5MNZ9, Q8R3E3 | |
| WIPI1 | |
| Recombinant protein corresponding to Human WIPI1. Recombinant protein control fragment (Product #RP-89638). | |
| 100 μL | |
| Primary | |
| Human, Mouse, Rat | |
| Antibody | |
| IgG |
Safety and Handling
WARNING: Cancer - www.P65Warnings.ca.gov
Product Content Correction
Your input is important to us. Please complete this form to provide feedback related to the content on this product.
Product Title
Spot an opportunity for improvement?Share a Content Correction